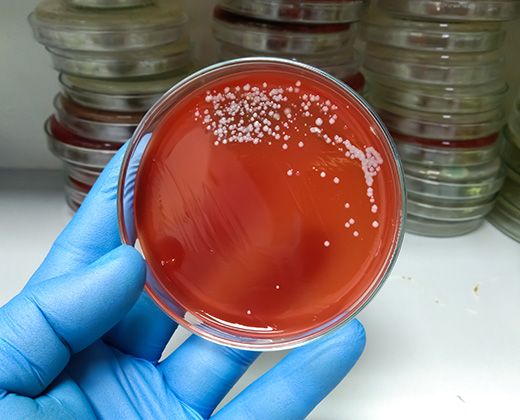

Beckenboden und Rückenschmerzen – wie alles zusammenhängt
Rückenschmerzen zählen zu den häufigsten Beschwerden im Alltag – doch nur wenige Betroffene wissen, dass die Ursache nicht immer in der Wirbelsäule selbst liegt. Ein oft unterschätzter Mitspieler in diesem Zusammenhang ist der Beckenboden. Als Teil der tiefen Rumpfmuskulatur trägt er maßgeblich zur Stabilität des Körpers bei – und beeinflusst somit auch direkt die Gesundheit des Rückens.